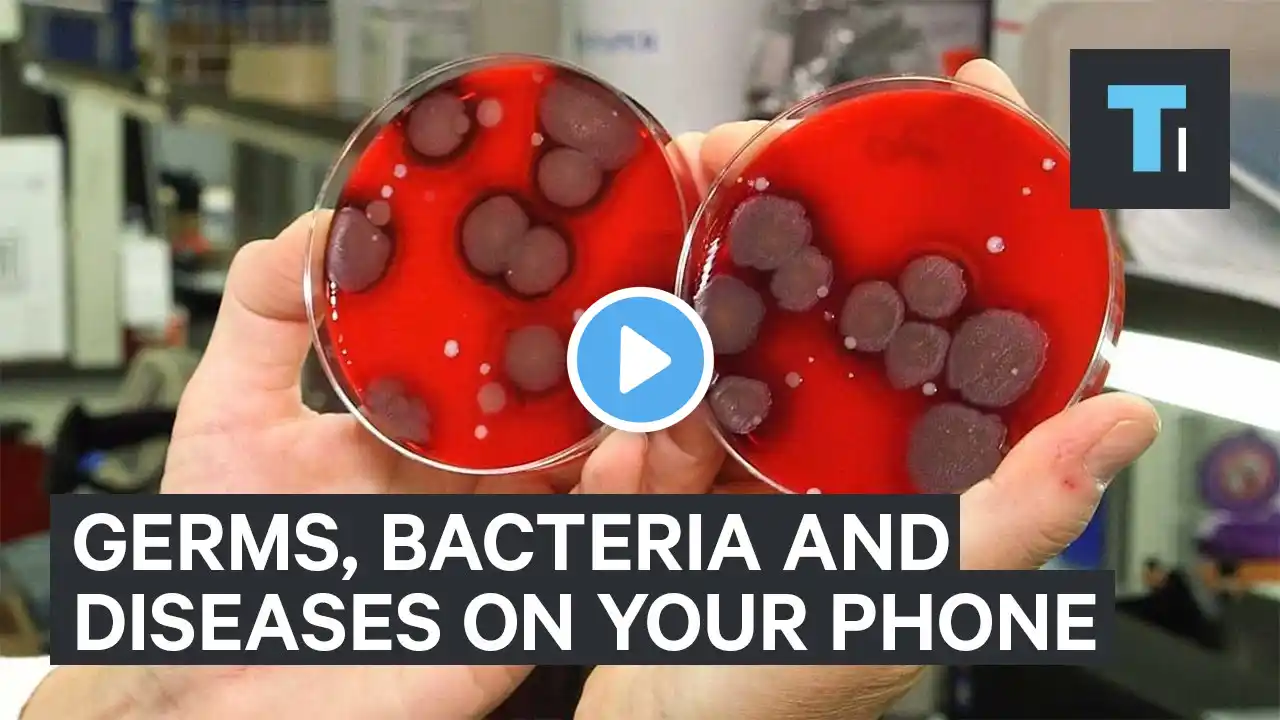
ภาพตัวอย่างวิดีโอ
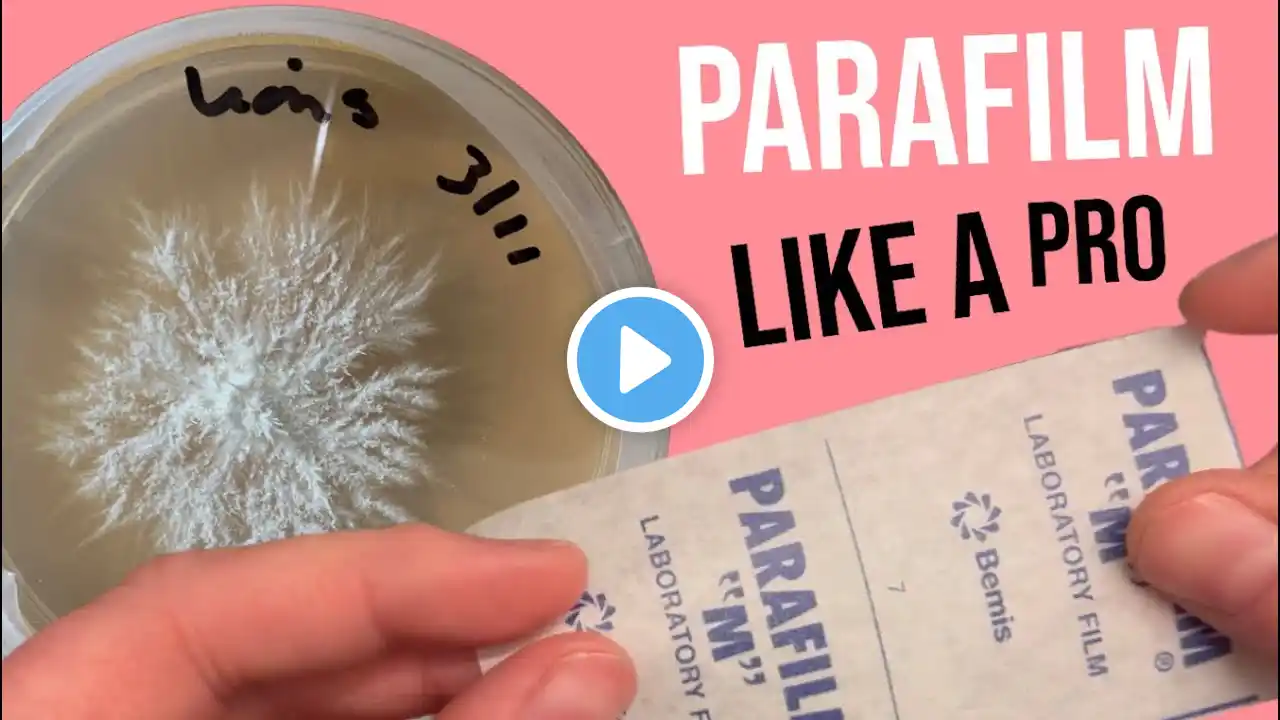
ภาพตัวอย่างวิดีโอ

Petri Dish Uses
#petridish Looking at the most common use of the Petri dish is to culture bacteria, fungi, and other microorganisms. Petri dishes provide a sterile environment for the growth of these organisms and are used to isolate and identify new microbial species website - Recombigen.com Contact Number - 9773839960 Thanks